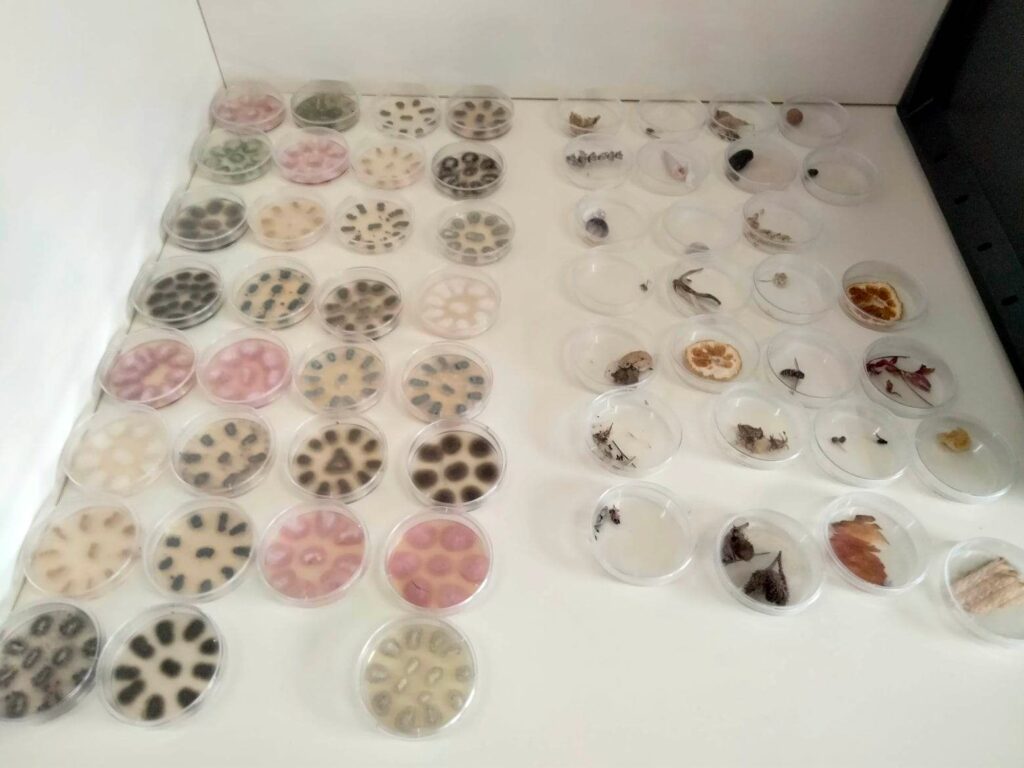

Prejšnji teden so učenci 9. razreda na naravoslovnem dnevu pobližje spoznali mikrobiologijo in biotehnologijo, ki sta med seboj tesno povezani in močno prisotni v našem vsakdanjem življenju. Učenci so spoznali mikroorganizme, njihove lastnosti in koristi, ki jih imajo za človeka ter praktične primere uporabe biotehnologije – kako si z njo pomagamo v medicini, kmetijstvu in industriji.
Na delavnicah so izvedli eksperiment »kvasne bombice« in z mikroskopi opazovali bakterije in plesni na gojišču. S pomočjo lego kock so se naučili, kako se zapis v DNK na ribosomih prevaja v proteine, in kako nastajajo in se izražajo mutacije.

[post-views]

